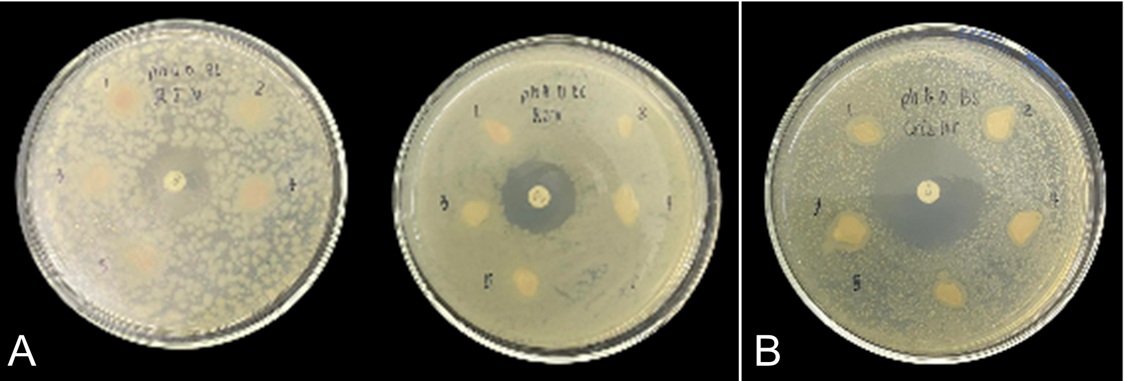

Vol. 9 No. 2 (2025): ARSHI Veterinary Letters - May 2025

Cover: Hafizsha N. L., & Nurfadhilah E. (2025). Diagnosis and treatment of suspected symmetrical peripheral gangrene in a Persian cat with feline infectious peritonitis. ARSHI Veterinary Letters, 9(2), 47-48.
ARSHI Veterinary Letters (ARSHI Vet Lett) (e-ISSN: 2581-2416) is an open-access, peer-reviewed journal published four times a year (February, May, August, and November) by the School of Veterinary Medicine and Biomedical Sciences, IPB University—formerly the Faculty of Veterinary Medicine (Rector Letter No. 328)—in collaboration with the Indonesian Veterinary Hospital Association (ARSHI). Established in 2017 and accredited SINTA 4 (Decree No. 79/E/KPT/2023, May 11, 2023), the journal focuses on clinical case–driven and practitioner-oriented studies in veterinary medicine. It aims to disseminate clinically relevant veterinary knowledge through case-based research, diagnostic innovations, and applied biomedical findings that bridge academic research and daily veterinary practice. ARSHI Vet Lett welcomes submissions covering not limited to case reports, clinical studies, diagnostic imaging, pathology, pharmacology, reproduction, zoonotic diseases, and biomedical innovations. All articles published in ARSHI Vet Lett has been indexed in: Crossreff, WorldCat, Scilit, Dimension, EBSCO, LensScholar, Garuda, Google Scholar, Microsoft Academia, and being process for other directory of research journal index

This work is licensed under a Creative Commons Attribution-ShareAlike 4.0 International License.